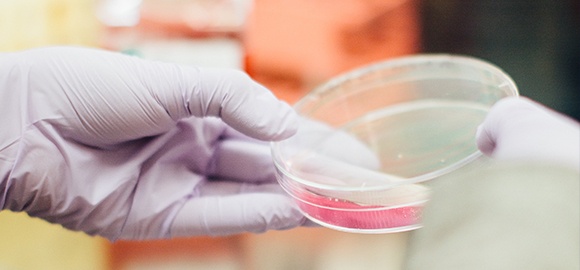

服務理念Service concept

用戶至上,用心服務
用戶需求放在第一位
用戶滿意就是我們的工作標準
創造價值
技術服務不是被動的售后跟進
更是創造價值的過程
主站蜘蛛池模板:
伊甸园成人入口
|
精品国产依人香蕉在线精品
|
欧美久久综合
|
精品99日产一卡2卡三卡4
|
国产精品毛片无遮挡高清
|
国产超碰人人做人人爱一二区视品
|
www国产精品
|
亚洲视频第二页
|
91视频免费观看
|
性色免费视频
|
亚洲欧美综合中文
|
无遮挡色视频免费观看
|
国产精品白丝喷水娇喘视频
|
日韩在线中文高清在线资源
|
精东影业精东传媒av
|
伊人久久精品无码二区麻豆
|
国产成人av无码永久免费一线天
|
国产一区二区三区视频在线观看
|
君岛美绪一区二区三区在线视频
|
九九只有精品
|
91丨九色丨蝌蚪丨对白
|
野外亲子乱子伦视频丶
|
日本高清一区二区视频
|
亚洲欧美激情网
|
国产欧美一区二区三区免费视频
|
日韩中文字幕在线一区二区三区
|
毛片女人18片毛片女人免费
|
最新在线观看av
|
成人白浆超碰人人人人
|
精品一区精品二区
|
日本三级免费网站
|
私色综合网
|
日韩欧美大片免费观看
|
99综合网
|
无码av在线一本无码
|
国产成人亚洲精品另类动态
|
欧美一区二区二区
|
天堂一区二区mv在线观看
|
国产精品日本
|
亚洲经典视频
|
久久亚洲精
|
欧美精品国产aⅴ一区二区在线
|
九久久久久
|
宅男噜噜噜66
|
超碰在线视屏
|
人人妻人人妻人人妻碰碰
|
97狠狠狠狼鲁亚洲综合网
|
亚洲色图另类图片
|
成人做爰高潮片免费视频美国
|
91大神精品在线
|
日本aⅴ免费视频一区二区三区
|
国产成人免费一区二区三区
|
中文字幕一区二区三区人妻少妇
|
人妻无码av中文系列久
|
日韩精品久久久久久久白丝
|
国产综合在线观看
|
亚洲色无码国产精品网站可下载
|
av在线播放中文字幕
|
亚洲综合成人婷婷小说
|
精品无人区卡一卡二卡三乱码
|
亚洲va中文字幕无码
|
99久久精品国产免费看
|
玩弄中年熟妇正在播放
|
黄色毛片网
|
2021国产成人精品久久
|
久久视频免费
|
99视频播放
|
国产综合视频在线观看
|
日韩久久在线
|
成人午夜高潮刺激免费视频
|
www.免费av
|
99re6在线视频精品免费下载
|
国产极品车模吞精高潮呻吟
|
污网站大全免费
|
亚洲视频一区在线播放
|
性饥渴的农村熟妇
|
国产一卡2卡3卡4卡网站贰佰
|
亚洲日韩一区二区一无码
|
国模gogo无码人体啪啪
|
97影院理论片手机在线观看
|
国产成人精品视频ⅴa片软件竹菊
|
性高朝久久久久久久
|
亚洲精品乱码久久久久久app
|
三上悠亚中文字幕在线播放
|
九九自拍偷拍
|
成 人 黄 色 免费 网站无毒
|
伊人网五月天
|
国产精品久久久久久二区
|
国产成人免费永久播放视频平台
|
久久婷婷五月综合色国产免费观看
|
亚洲激情视频一区
|
亚洲欧美日韩激情
|
日本色图在线
|
综合色爱
|
中文字幕在线亚洲
|
精品国产一区二区三区2021
|
亚洲国产综合久久久
|
久久久综合九色综合鬼色
|
中文字幕岛国
|
婷婷亚洲视频
|
国产制服丝袜欧美在线观看
|
天堂av在线官网
|
欧洲美女bbbbbbbbb
|
国产二区av
|
国产美女自卫慰黄网站
|
免费线上av|
欧美在线xxx
|
日韩免费无码一区二区视频
|
www.久久爱白液流出h好爽
|
日本久久久久久
|
中文在线а√天堂
|
宝宝好涨水快流出来免费视频
|
国产女人高潮抽搐喷水视频
|
无人乱码一区二区三区的观看模式
|
国模国产精品嫩模大尺度视频
|
日本黄xxxxxxxxx100
|
少妇被爽到高潮喷水久久欧美精品
|
天堂av影院
|
中文字幕日韩精品一区二区三区
|
国产精品九一
|
成人福利动态图啪啪gif看了吧
|
免费人成在线观看网站品善网
|
色猫咪av在线观看
|
精品无码国产污污污免费
|
中文无码精品a∨在线观看
国产成人精品亚洲日本语言
|
99热久久这里只精品国产www
|
干日本少妇|
成人免费av网站
|
xxxx69国产
|
亚洲精品久久久一区
|
av密臀
|
午夜影院免费在线观看
|
成人一区二区免费中文字幕视频
|
夜色福利站www国产在线视频
|
91久久久久久久久久
|
亚洲精品国产乱码av在线观看
|
欧美老妇bbbwwbbbww|
午夜在线观看网站
|
少妇又色又爽又黄的视频
|
骚虎视频在线观看
|
精品人妻无码一区二区三区9
|
久亚洲一线产区二线产区三线产区
|
日本艳妓bbw高潮一19
|
www,四虎
|
国产成人精品一区二区秒播
|
伊人久久大香线蕉av色婷婷色
|
亚洲国产成人一区二区精品区
|
日韩视频免费观看
|
国产成人精品午夜片在线观看
|
亚洲欧洲在线播放
|
国产成人综合久久精品推
|
欧美aa在线|
西西人体做爰大胆性自慰
|
亚洲精品国产高清在线观看
|
久久精品国产99久久丝袜
|
onlytease欧美丝袜福利
|
四虎在线永久免费观看
|
国产另类视频
|
国模小黎大尺度精品(02)[82p]
|
五月婷婷色播
|
国产萌白酱喷水视频在线播放
|
精品福利一区二区三区
|
日韩欧美在线不卡
|
亚洲一区亚洲二区
|
草草影院国产第一页
|
国产午夜精品理论片久久影院
|
少妇中文字幕乱码亚洲影视
|
久久久久久久无码高潮
|
久久www色情成人免费观看
|
少妇人妻14页_麻花色
|
婷婷在线观看视频
|
久久国产一级片
|
久久精品无码一区二区www
|
黑人巨大精品欧美一区二区三区
|
精品国偷自产在线
|
西野翔之公侵犯中文字幕
|
久久亚洲道色综合久久
|
天天av天天翘天天综合网色鬼
|
成人欧美一区二区三区黑人动态图
|
精品玖玖玖视频在线观看
|
免费人成视频x8x8入口
|
国产午夜高潮熟女精品av软件
|
成人免费淫片aa视频免费
|
国产精成人品日日拍夜夜
|
国产性精品|
日本涩涩网站
|
亚洲另类自拍丝袜第五页
|
国产av毛片亚洲含羞草社
|
国产成av人片在线观看无码
|
黄片毛片在线免费观看
|
99热这里只有精品4
波多野吉衣av在线
国色天香一卡2卡三卡4卡乱码
|
窝窝影院午夜看片
|
超碰97久久
|
激情综合网婷婷
|
欧美高清a
|
国产激情视频一区二区三区
|
综合亚洲综合图区网友自拍
|
综合激情在线
|
久久免费99精品国产自在现线
|
内射小寡妇无码
|
熟妇人妻无乱码中文字幕
|
在线观看日韩
|
五月天婷婷基地
|
国产成人精品自产拍在线观看
|
91色站|
蜜臀av性久久久久蜜臀aⅴ麻豆
|
久久精品国产亚洲a∨蜜臀
免费看黄色片视频
|
欧美肉欲k8播放毛片欧美
|
亚洲欧美在线观看品
|
日韩欧美在线免费观看
|
99热热久久
|
国产精品成人片在线观看
|
精品视频一区二区三区在线观看
|
天堂在/线中文在线资源8
|
国产00粉嫩馒头一线天萌白酱
|
日本黄色大片免费
|
九色porny丨国产首页在线
|
一本久草
|
av丝袜在线观看
|
黑人性猛爱xxxxx免费
|
国产一区二区三区四区在线观看
|
www五月天婷婷
|
青草热视频
|
最新国产乱人伦偷精品免费网站
|
精品人伦一区二区三区蜜桃视频
|
老牛嫩草二区三区观影体验
|
日韩成人精品在线观看
|
丰满少妇小早川怜子影片了
|
日产精品99久久久久久
|
最新国产av无码专区亚洲
|
国产女人叫床高潮视频在线观看
|
欧美日韩国产精品激情在线播放
|
五月婷婷六月丁香动漫
|
國产一二三内射在线看片
|
国产亚洲综合av
|
手机看片日韩
|
国产特级毛片aaaaaa高潮流水
|
亚洲精品嫩草研究院久久
|
国产精品久久久久久在线观看
|
日韩精品无码视频一区二区蜜桃
|
www.国产在线视频
|
69久久成人精品
|
天天天天综合
|
国产福利小视频在线
|
欧美女人性生活视频
|
伊人久久大线影院首页
|
精品人妻午夜一区二区三区四区
|
在线播放你懂
|
久久精品国产精品亚洲色婷婷
|
欧美不卡激情三级在线观看
|
亚洲久热中文字幕在线
|
免费黄色网页
|
福利姬国产精品一区在线
|
女被男啪到哭的视频网站
|
偷国产乱人伦偷精品视频
|
国产精品人人妻人人爽人人牛
|
亚洲国产色图
|
久久婷婷五月综合色和啪
|
亚洲精品一区二区三区无码a片
|
99riav在线
|
巨乳人妻久久+av中文字幕
|
黑人巨大精品oideo
|
国产白丝无码视频在线观看
|
亚洲欧美日韩国产精品b站在线看
|
小泽玛利亚一区二区在线观看
|
欧美亚洲国产手机在线有码
|
日韩欧美精品一区二区三区经典
|
天天槽夜夜槽槽不停
|
www.午夜精品|
亚洲高清自有吗中文字
|
调教凌虐羞辱少妇
|
国产欧美一区二区三区在线看蜜臀
|
少妇xxxhd中国
|
日本婷婷免费久久毛片
|
精品综合久久久久久888
|
久久精品久久精品久久39
|
国产精品久久久久久久久久综合
|
色喜国模李晴超大尺度
|
日日日日日日bbbbb视频
|
国产无套白浆视频在线观看
|
少妇高潮毛片高清免费播放
|
青青草视频在线免费播放
|
欧美成人综合一区
|
视频在线观看一区二区
|
国产精品夜夜春夜夜爽久久
|
成人黄色免费在线观看
|
亚洲性xxxx
|
久久www成人_看片免费不卡
|
4438ⅹ亚洲全国最大色丁香
|
中文字幕影片免费在线观看
|
人妻精品久久无码专区涩涩
|
男人天堂国产
|
一本大道久久久久精品嫩草
|
黄色男女 黄色a几
|
十八禁在线观看视频播放免费
|
中文字幕av一区二区
|
永久免费观看的毛片视频
|
青青草视频免费在线观看
|
日本欧美韩国国产精品
|
人妻有码av中文字幕久久琪
|
国产精品日韩专区第一页
|
在线成人www免费观看视频
|
伊甸园成人入口
|
高清无码爆乳潮喷在线观看
|
日韩最新在线
|
国产亚洲色欲色一色www
|
91丨porny丨成人蝌蚪
|
国产精品成人免费看片
|
青青草原亚洲视频
|
天天撸日日夜夜
|
人人妻人人爽人人爽
|
欧美孕妇xxxx做受欧美88
|
污18禁污色黄网站免费观看
|
国产精品无码无需播放器
|
亚洲综合日韩精品欧美综合区
|
日本成熟少妇喷浆视频
|
在线观看岛国av
|
亚洲日b
|
老子影院午夜伦手机不四虎卡
|
天堂av无码av在线a√
|
韩国精品福利一区二区三区
|
7777久久久国产精品消防器材
|
中出在线播放
|
国产精品久久久久亚洲影视
|
饥渴少妇高潮视频大全
|
强开小受嫩苞第一次免费视频
|
日本天天射
|
av无码午夜福利一区二区三区
|
中文字幕无码人妻aaa片
|
欧美亚洲国产另类
|
久久久久黑人强伦姧人妻
|
www.青草视频
|
蜜桃av一区二区三区www
|
中日字幕大片在线播放
|
永久免费无码网站在线观看
|
99热这里只有精品99
|
色多多在线观看视频
|
国产成人综合怡春院精品
|
www·59com嫩草影院|
av导航福利
|
久久精品国产福利国产秒拍
|
中文字幕国产精品视频
|
99久热在线精品视频观看
|
偷拍老熟妇和小伙xxxx视频
|
中文乱码免费一区二区三区
|
久久性生活片
|
www.av在线
|
国产伦精品免编号公布
|
在线日本国产成人免费不卡
|
亚洲国产老鸭窝一区二区三区
|
国产欧美精品一区二区色综合
|
亚洲成a人片777777张柏芝
|
亚洲欧美国产精品久久久久久久
|
中文字幕精品一区二区的区别
|
一边摸一边抽搐一进一出口述
|
暖暖 在线 日本 免费 中文
|
老司机一区二区三区
|
亚洲国产日韩精品
|
久久99精品久久久久婷婷
|
99久久精品6在线播放
|
国产欧美综合在线
|
狠狠搞av|
天天干天天操天天干
|
国产精品成人av在线观看春天
|
福利视频自拍
|
亚洲第一极品精品无码
|
毛片其地
|
永久免费无码网站在线观看个
|
久久中文字幕无码一区二区
|
国产午夜福利片
|
欧美日韩免费一区二区
|
国产精品毛片久久久
|
国产91免费|
免费三级网站
|
国产裸体瑜伽xxx在线
|
国产亚洲欧美另类一区二区三区
|
亚洲欧洲日产国码无码app
|
久久久久国产精品
|
亚洲高清一区二区三区不卡
|
久久久久久免费精品
|
婷婷玖玖
|
国产精品天干在线观看
|
97国产真实伦对白精彩视频8
|
中文字幕免费在线视频
|
成人网av
|
欧美婷婷六月丁香综合色
|
午夜免费福利网站
|
国产精品久久久久精
|
国产自偷在线拍精品热
|
亚洲妇女行蜜桃av网网站
|
欧美日本特级婬片视频
|
国产一区二区三区视频
|
亚洲国产精品成人久久久麻豆
|
久热爱精品视频在线◇
|
成人精品一区二区久久久
|
免费在线黄色片
|
亚洲人人|
亚洲一区二区福利
|
中国一区二区三区
|
国产一区二区三区色淫影院
|
国模一区二区三区四区
|
奇米影视第4色
|
av中文字幕网免费观看
|
成人午夜精品久久久久久久
|
日日噜噜噜夜夜爽爽狠狠同性男
|
久久伊人精品青青草原vr
|
最新 国产 精品 精品 视频
|
老司机深夜福利影院
|
99久久久无码国产精品不卡
|
华人在线视频
|
91啦视频|
亚洲日韩av无码一区二区三区
|
亚洲成av人片在线观看ww
|
少妇高潮无套无遮挡内谢小说
|
72种姿势欧美久久久久大黄蕉
|
亚洲综合国产成人丁香五月激情
|
国产欧美三级
|
国产cao|
精品国偷自产在线
|
上司侵犯下属人妻中文字幕
|
国产精品二区在线
|
国产亚洲精品久久久久久武则天
|
精品久久久久久天美传媒
|
国产精品久久久久久中文字
|
欧美成人怡红院一区二区
|
国产精品入口麻豆www
|
火箭视频在线观看精品
|
日本大乳爱
|
久久久综综合色一本伊人
|
欧美视频区高清视频播放
|
香蕉在线播放
|
日韩高清一|
裸体黄色片|
日韩网站免费观看
|
波多野结衣av一区二区无码
|
久久成人国产精品免费软件
|
日本乱偷人妻中文字幕
|
91午夜在线|
国产在线观看不卡
|
欧美成人手机在线
|
亚洲色无码专区在线观看
|
亚洲精品天堂无码中文字幕
|
在线欧美精品一区二区三区
|
美女18免费视频
|
色 亚洲 日韩 国产 综合
|
亚洲精品国产情侣av在线
|
日韩经典中文字幕
|
第一福利丝瓜av导航
|
日韩av中文无码影院
|
亚洲高清码在线精品av
|
九九热视频在线播放
|
一级大片免费看
|
日韩免费无码一区二区视频
|
9191在线视频
|
亚洲精品一区二区国产精华液
|
看黄网站在线观看
|
青青草国产在线视频
|
四只虎影院在线免费
|
久一国产
|
aaa日本高清在线播放免费观看
|
www性欧美
|
蜜桃成人在线视频
|
日本hd好看的国产的
|
av黄色在线免费观看
|
最新日韩av在线
|
超碰人人射
|
裸体精品bbbbbbbbb
|
久久人成
|
国产精品伦一区二区三级视频永妇
|
久久精品a一国产成人免费网站
|
福利亚洲
|
伊人久久综合无码成人网
|
丰满圆润自拍少妇啪啪xxx
|
免费看黄色毛片
|
丰满少妇aaaaaa爰片毛片
|
国产一级片播放
|
97久久国产成人免费网站
|
台湾佬自拍偷区亚洲综合
|
偷偷久久|
欧美v成 人在线观看
|
国产福利在线永久视频
|
真人毛毛片|
国产成人无码av一区二区
|
亚洲日韩久久综合中文字幕
|
99热这里
|
国产suv精二区一片
国产成人久久精品77777的功能
|
新四虎
|
久久久久av无码免费网
|
老司机久久精品视频
|
亚洲一区二区日本
|
玩弄人妻少妇500系列网址
|
国产视频a区
|
国产精品久久久久久久久久红粉
|
www.在线色|
伊人小视频
|
欧洲一区二区三区
|
亚洲一区二区三区四区五区午夜
|
久久伊人精品视频
|
人人干人人噪人人摸
|
永久555www成人免费
|
91久久久一线二线三线品牌
|
成人a v视频在线观看
|
一本色道88久久加勒比精品
|
亚洲中文字幕无码久久精品1
|
欧美乱大交做爰xxxⅹ性3
|
色老久久精品偷偷鲁
|
爱看av在线入口
|
黄色va视频
|
精品香蕉久久久爽爽
|
老子影院午夜伦不卡
|
99热官网
|
欧美日韩生活片
|
无码粉嫩虎白一线天在线观看
|
国产精品 视频一区 二区三区
|
亚洲精品无码人妻无码
|
国产精品人妻
|
国产乱人无码伦av在线a
|
国产精选第一页
|
黄色片免费在线
|
欧美色欧美亚洲高清在线观看
|
成人午夜亚洲精品无码区
|
熟妇的奶头又大又长奶水视频
|
日韩av一区二区在线
|
青青草无码精品伊人久久蜜臀
|
亚洲男人
|
欧美色图校园春色
|
国产在线成人
|
av成人免费网站
|
日日夜夜狠
|
高清同性男毛片
|
色一情一区二区三区四区
|
国产做爰全过程免费视频
|
日本妇乱大交xxxxx
|
热久久中文字幕
|
在线播放中文字幕
|
亚洲欧美黑人猛交群
|
国产美女被遭高潮免费网站
|
中文字幕亚洲情99在线
|
日韩中文字幕a
|
色综合天天综合网天天狠天天
|
伊人性视频
|
精品人妻少妇嫩草av无码专区
|
www.亚洲色图
|
18禁黄网站禁片免费观看国产
|
女厕偷窥一区二区三区
|
91av中文字幕|
国产精品海角社区在线观看
|
亚洲情侣在线
|
4hu44四虎www在线影院麻豆
|
97人人模人人爽人人喊电影
|
草草久久久无码国产专区
|
欧美va天堂在线电影
|
91网站在线播放
|
www久久九|
亚洲欧洲综合网
|
激情综合婷婷丁香五月
|
九月色婷婷
|
特级西西人体444www高清
|
免费看国产黄色片
|
亚洲精品无码高潮喷水a片软
|
九色porny丨天天更新
|
av人摸人人人澡人人超碰小说
|
亚洲综合久久一区二区
|
免费无遮挡无码永久视频
|
日本xxxxxxxx免费视频
|
可以免费看毛片的网站
|
欧美肥富婆丰满xxxxx
|
91久久国产综合久久91
|
无码国产精成人午夜视频不卡
|
永久免费看黄
|
色播视频在线
|
伊人91在线
|
国产人妻人伦精品
|
亚洲国产成人久久综合下载
|
亚洲一区二区三区四区五区六区
|
欧美午夜片欧美片在线观看
|
国产成人avxxxxx在线看
|
久久66热人妻偷产精品9
|
www.av视频在线观看
|
国内精品久久久久久久日韩
|
国产av一区二区三区
|
中文字幕无线观看不卡网站
|
国产成人片无码视频
|
国产精品白丝av嫩草影院
|
亚洲男女羞羞无遮挡久久丫
|
久久久久久久久久网
|
国产一二区在线
|
懂色av一区二区在线播放
|
av日韩免费在线观看
|
亚洲人成在线播放网站
|
青青毛片
|
777狠狠
|
看一级黄色片
|
男人的天堂久久
|
女人被狂躁到高潮视频免费无遮挡
|
丰满人妻被中出中文字幕
|
亚洲视频网址
|
激情综合网激情
|
成人精品二区
|
久久久久久久99精品免费观看
|
亚洲第一毛片18我少妇
|
www.日韩.com
|
久久精品国产麻豆
|
中字幕视频在线永久在线
|
免费无码a片一区二三区
|
aⅴ亚洲 日韩 色 图网站 播放
|
亚洲综合色站
|
www.狠狠色|
葵司有码中文字幕二三区
|
8av国产精品爽爽ⅴa在线观看
|
国产av老师丝袜美腿丝袜
|
国产午夜精品一区二区三区漫画
|
中文字幕日韩av在线
|
av一区二
|
欧美日韩中文字幕在线
|
1区1区3区4区产品乱码芒果精品
|
午夜福利精品导航凹凸
|
国产亲子乱弄免费视频
|
日韩h在线
|
手机福利视频
|
三日本三级少妇三级99
|
91高清免费|
亚洲图片一区二区
|
在线亚洲+欧美+日本专区
|
国产精品 欧美精品
|
成人黄色激情小说
|
亚洲天堂伊人
|
久久久精品美女
|
欧美怡红院一区二区三区
|
人妻熟女一区二区aⅴ林晓雪
|
日本a级毛片视频播放
|
男女野外做爰全过程69影院
|
国内毛片毛片毛片毛片毛片毛片
|
91精品国产综合久久久蜜臀图片
|
91最新视频在线观看
|
青草国产超碰人人添人人碱
|
欧美日性视频
|
性农村xxxxx小树林
|
老牛嫩草一区二区三区消防
|
日日噜夜夜爽精品一区
|
91免费版黄
|
av鲁丝一区鲁丝二区鲁丝三区
|
成人精品v视频在线
|
2021av在线无码最新
|
欧美一区二区三区另类
|
一区二区三区毛片
|
性欧美videos武则天
|
天天综合网日韩
|
精品国产1区2区
|
交换交换乱杂烩系列yy
|
99久久精品费精品国产一区二
|
老太婆性杂交欧美肥老太
|
亚洲日本中文字幕乱码在线电影
|
91九色首页
|
十八禁啪啪无遮挡网站
|
国产美女无遮挡网站
|
国产精品国产三级国产专播品爱网
|
99久久国产综合精品尤物酒店
|
99免费看
|
又粗又黑又大的吊av
|
97超碰中文字幕
|
日日碰狠狠添天天爽不卡
|
亚欧日韩
|
亚洲一卡2卡三卡四卡精品
97se狠狠狠综合亚洲狠狠
|
无码色av一二区在线播放
|
欧洲熟妇性色黄在线观看免费
|
国产精品精品
|
亚洲精品国产成人99久久
|
亚洲中文久久久精品无码
|
国产精品香蕉在线观看网
|
日本精品久久久久中文字幕5
|
哈尔滨老熟女啪啪嗷嗷叫
|
蓝av导航a√第一福利网
|
免费无码久久成人影片
|
你懂的在线免费观看
|
亚洲精品字幕
|
韩国美女啪啪
|
av私库在线观看
|
12一15性xxxx粉嫩国产
|
真人无码作爱免费视频网站
|
久久国产36精品色熟妇
|
无码乱码天天更新
|
欧美日韩人成视频在线播放
|
高清一区二区三区四区
|
五月天久久
|
国产三级韩国三级日产三级
|
成人无码av片在线观看
|
伊人久久大香线蕉综合影院首页
|
亚洲熟妇无码av不卡在线
|
欧美成 人影片 aⅴ免费观看
|
无套内内射视频网站
|
亚洲人成网7777777国产
|
精品国产免费人成网站
|
国产熟女亚洲精品麻豆
|
国产成人av网站网址
|
人人妻人人做人人爽精品
|
久久av无码精品人妻出轨
|
成人a8198va
|
人妻大战黑人白浆狂泄
|
无码综合天天久久综合网色吧影院
|
亚洲国产精品色拍网站
|
粉嫩av一区二区在线播
|
最新精品国偷自产在线老年人
|
免费观看潮喷到高潮中文字幕
|
男男gv在线播放网站亚洲
|
日本网站在线免费观看
|
99亚洲精品久久久99
|
午夜资源网
|
黄色特一级片
|
国产系列丝袜熟女精品网站
|
婷婷亚洲综合五月天小说
|
久久av激情
|
久久综合九色综合欧美亚洲
|
精品国产一二三产品区别在哪
|
久一国产
|
国产日韩在线免费观看
|
成人羞羞国产免费动态
|
中文字幕一本性无码
|
毛片天堂
|
国产精品天天av精麻传媒
|
日本熟熟妇xxxxx精品熟妇
|
亚洲精品国产精品国产自
|
人人妻人人超人人
|
欧美人与物∨ideos另类3
|
色偷偷色偷偷色偷偷在线视频
|
东北少妇av|
亚洲精品欧美一区二区三区
|
伊人称影院
|
尹人综合在线
|
国产小视频在线观看免费
|
少妇无内裤下蹲露大唇92
|
黄色国产大片
|
亚洲性综合
|
av女优天堂在线观看
|
激情无码人妻又粗又大中国人
|
国产成人a∨激情视频厨房
樱花草涩涩www在线播放
|
日本新janpanese乱熟
|
你懂的手机在线观看
|
伊人亚洲
|
日本欧美一级aaaaa毛片
|
久久久久无码精品国产不卡
|
伊人中文在线
|
亚洲永久在线观看
|
国产亚洲精品岁国产微拍精品
|
av网站有哪些
|
日本黄色录相
|
黄色毛片在线观看
|
亚洲在线中文字幕
|
五月激情综合网
|
日韩在线一二三区
|
青青草视频免费播放
|
高h喷水荡肉爽文np肉色学校
|
国产日韩欧美亚洲
|
国产69精品久久久久观看软件
|
极品少妇被黑人白浆直流
|
国产亚洲欧美日韩精品一区二区
|
亚洲男人的天堂在线va
|
欧美日韩亚洲中文字幕一区二区三区
|
精品国产成人一区二区
|
天堂资源在线官网
|
欧洲熟妇色xxxxx欧美
|
色婷婷免费
|
在线看你懂得
|
国产强伦人妻毛片
|
婷婷开心中文字幕
|
麻豆传煤入口免费进入2023
|
亚洲成在人线av
|
亚洲人成人网站色www
|
亚洲国产精品久久久久久6q
|
91视频黄污
|
无码ol丝袜高跟秘书在线观看
|
久操综合
|
国产精品无码av在线播放
|
天堂在线www天堂中文在线
|
国产福利91精品一区区二区三国产s
|
9999在线观看
|
国产思思
|
国产精彩视频一区
|
永久免费观看美女裸体的网站
|
中文字幕在线免费看
|
美女黄色免费网站
|
国精品无码一区二区三区在线a片
|
久久精品国产99国产电影网
|
亚洲乱妇熟女爽到高潮的片
|
亚洲制服无码一区二区三区
|
av中文字幕一区二区三区
|
68精品久久久久久欧美
|
在线a亚洲视频播放在线观看
|
美女屁股隐私免费视频
|
美日欧激情av大片免费观看
|
爱色av.com
|
欧美日本韩国一二区视频
|
97成人在线观看
|
国产911情侣拍拍在线播放
|
亚洲国产日韩a在线乱码
|
国模冰莲自慰肥美胞极品人体图
|
激情丁香网
|
国产精品一色哟哟
|
在线观看欧美国产
|
日夜夜操
|
国91精品久久久久9999不卡
|
人妻无码αv中文字幕久久
久久黄色一级片
|
免费a级毛片出奶水
|
欧美伦理一区二区三区
|
亚洲狼人伊人中文字幕
|
337p日本欧洲亚洲大胆人人
|
免费高清av一区二区三区
|
欧美亚洲久久
|
尤物九九久久国产精品
|
香蕉免费一区二区三区在
|
99欧美视频
|
狠狠插综合网
|
国产成人精品123区免费视频
|
日本少妇春药特殊按摩3
|
激情欧美一区二区三区黑长吊
|
欧美aa在线观看
|
日韩人妻无码中文字幕一区
|
免费国产h视频在线观看
|
日日操日日摸
|
国产无套水多在线观看
|
国产精品高潮呻吟视频
|
久久久精品成人免费观看
|
超碰欧美|
精品免费一区二区在线
|
玖玖玖精品
|
国产精品成av人在线视午夜片
|
h动漫无遮挡成本人h视频
|
激情另类视频
|
国产又粗又硬又大爽黄老大爷视频
|
日本熟妇色高清播放
|
国产精品拍国产拍拍偷
|
精品国产乱码久久久久久闺蜜
|
亚洲再线
|
成人福利在线视频
|
无码高潮又爽又黄a片软件
中国黄色三级毛片
|
亚洲国产色婷婷
|
伊人网在线播放
|
欧美激情一区二区三级高清视频
|
男女性爽大片视频免费看
|
日产久久视频
|
www.热久久
|
www国产亚洲精品久久麻豆
|
在线精产国品
|
囯产精品一品二区三区
|
久久香蕉综合色一综合色88
|
97色爱|
人人干人人玩
|
成人做爰高潮片免费看
|
国产专区av
|
www国产在线观看
|
在线观看欧美黄色
|
亚洲va在线va天堂va欧美va
|
午夜精品极品粉嫩国产尤物
|
亚洲欧美一区二区三区
|
九九天堂
|
九九视频免费在线观看
|
成品人片a91观看入口888
|
2020精品自拍视频曝光
|
国产精品99久久
|
免费伊人|
强开乳罩摸双乳吃奶网站
|
7777久久久国产精品消防器材
|
青青国产在线观看
|
精品久久久久一区二区国产
|
四虎国产精品免费久久
|
成人午夜免费毛片
|
欧洲肉欲k8播放毛片
|
粉嫩av亚洲一区二区图片
|
国产成人av激情在线播放
|
亚洲热在线观看
|
亚洲成人诱惑
|
东北少妇露脸无套对白
|
日韩中文字幕成人免费视频
|
欧美色就是色
|
国产成人无码a区精油按摩
日韩色片在线
|
色综合色狠狠天天综合网
|
337p日本大胆欧久久
|
狠狠色网站
|
一个人看的www片免费高清视频
|
国产大爆乳大爆乳在线播放
|
东北农村女人乱淫免费视频
|
国产精品久久久久久久久久白浆
|
蜜臀久久99精品久久久无需会员
|
中国少妇xxxⅹ性xxxx
|
成av在线
|
在线看的免费网站
|
学生丨6一毛片
|
国产精一品亚洲二区在线播放
|
欧美日韩国产第一区
|
亚洲中文字幕无码爆乳av
|
男女做爰无遮挡性视频
|
四虎影院永久网站
|
甜蜜惩罚 在线观看
|
国产国产国产国产系列
|
一区二区三区国产最好的精华液色
|
91美女在线
|
亚洲成年人
|
欧美一区在线视频
|
国产精品88久久久久久妇女
|
日韩a无v码在线播放
|
亚洲人成人无码网www电影首页
|
一级黄色片在线看
|
天堂在线最新版www中文
|
亚洲日本va午夜在线电影
|
午夜性爽爽爽爽爱爱爱爱
|
色yeye香蕉凹凸视频在线观看
|
91视频专区|
亚洲一区二区三区免费视频
|
国产一区二区在线免费观看
|
五月婷婷色
|
日本大乳免费观看久久99
|
亚洲综合国产成人无码
|
日韩二区三区
|
在线播放亚洲第一字幕
|
91porn国产成人
|
欧美一区二区在线观看视频
|
4hu新地址|
午夜性色福利在线视频福利
|
国产精品丝袜综合区旗袍
|
欧美老妇交乱视频在线观看
|
深夜放纵内射少妇
|
日韩内射美女片在线观看网站
|
97久久久久人妻精品区一
|
午夜视频在线网站
|
久久久a级片
|
67194熟妇人妻欧美日韩
|
久久久www
|
最新国产精品精品视频 视频
|
国产日韩欧美成人
|
国产一区二区三区精品毛片
|
国产精品美女一区
|
国产精品18久久久久久白浆动漫
|
国产极品美女高潮抽搐免费网站
|
av老司机在线观看
|
国产精品任我爽爆在线播放,
|
国产成人亚洲综合无码精品
|
亚洲精品国男人在线视频
|
乱码一卡二卡新区永久入口
|
蜜桃精品免费久久久久影院
|
强行糟蹋人妻hd中文字幕
|
国产麻豆一区二区三区在线观看
|
女人喷潮完整视频
|
欧美系列在线观看
|
亚洲一区在线视频观看
|
人妻少妇乱子伦精品无码专区电影
|
欧美精品中文字幕在线视
|
天天色天天操天天射
|
黄色综合
|
天天澡天天摸天天添视频
|
中文www新版资源在线
|
久久久国产一级片
|
秋霞激情|
欧美日韩精品一区二区三区
|
水蜜桃亚洲精品一区二区
|
国产精品偷伦视频免费手机播放
|
在线中文字幕有码中文
|
久久av无码精品人妻糸列
|
国产午夜精品一区二区三区老
|
日韩精品亚洲人旧成在线
|
av片手机在线观看
|
97超碰中文字幕久久精品
|
天天爱天天做天天爽
|
无码人妻一区二区三区线
|
非洲黑人性xxxx精品
|
www.av视频|
国产精品人成视频免费国产
|
超碰一级片
|
国产精品永久在线观看
|
国产真人无码作爱免费视频
|
成色视频
|
在线播放你懂的
|
jizz亚洲少妇
|
国产成人无码激情视频
|
人妻人人看人妻人人添
|
91精品国产麻豆国产自产在线
|
男人添女人囗交做爰视频
|
欧美天天影院
|
亚洲另类丝袜综合网
|
亚洲另类激情小说
|
国产suv精品一区二区60
|
婷婷网色偷偷久久久99超碰
|
国产精品视频专区
|
无遮挡h肉动漫在线观看
|
久久久精品妓女影院妓女网
|
国产精品伦子伦免费视频
|
天天综合网入口
|
亚洲成人av片
|
国产一区二区怡红院
|
欧美一区2区三区4区公司
|
国产精品美女久久久久久福利
|
国产69精品久久久久app下载
|
青青草视频网
|
免费的一级片
|
色综合av社区男人的天堂
|
天堂资源中文在线
|
久久人人爽人人爽人人片亞洲
|
瑟瑟在线视频
|
www.这里只有精品
|
国产精品高跟丝袜一区
|
久久无码av一区二区三区
|
亚洲精品av无码喷奶水糖心
|
亚洲人成在线观看网站无码
|
久久视频这里有精品
|
日韩中文字幕在线观看视频
|
亚洲欧美高清一区二区三区
|
久草资源福利站
|
免费看一区无码无a片www
|
91精品国产日韩91久久久久久
|
人妻天天爽夜夜爽一区二区
|
亚洲a一区
|
国产成人三级在线观看视频
|
天天躁夜夜躁狠狠眼泪
|
久久婷婷狠狠综合激情
|
亚洲国产精品高潮呻吟久久
|
伊人啪啪
|
狠狠操狠狠色
|
九九色综合网
|
日本在线www
|
野外少妇愉情中文字幕
|
日韩在线精品视频
|
色综合热无码热国产
|
九九热播视频
|
免费毛片一区二区三区亚女同
|
中文字幕久久久人伦
|
日韩av动漫
|
久久99精品久久久久免费
|
国产一区二区伦理
|
五色影院
|
精品区一区二
|
欧洲美女熟乱av
|
中文字幕无码精品亚洲资源网久久
|
女人高潮被爽到呻吟在线观看
|
9色porny自拍视频一区二区
|
性bbbbwwbbbb|
操碰在线视频
|
日韩在线观看第一页
|
亚洲国产午夜
|
99久久人妻精品免费一区
|
久久久久人妻一区精品
|
国产又粗又猛又大爽视频
|
99亚洲男女激情在线观看
|
天码av无码一区二区三区四区
|
成视频年人黄网站免费视频
|
久久爱九九伊人
|
东北老女人高潮对白dvd
|
一区二区三区四区五区在线视频
|
尤物网站在线播放
|
欧美三区四区
|
日本人与黑人做爰视频网站
|
午夜爽视频
|
制服丝袜人妻中文字幕在线
|
国产欧美精品
|
忘忧草社区中文字幕www
|
五月激情五月婷婷
|
亚洲成在人线天堂网站
|
狠狠爱天天综合色欲网
|
色综合久久无码中文字幕app
|
色五五月
|
在线99
|
国产精品亚洲а∨无码播放不卡
|
亚洲成人久
|
青青草无码国产亚洲
|
久久伊人婷婷
|
无码人妻精品一二三区免费
|
小说区 亚洲 自拍 另类
|
精品视频中文字幕
|
偷窥丰满女邻居少妇洗澡
|
欧美一区二区免费视频
|
伊人久久综合精品无码av专区
|
国产精品毛片va一区二区三区
|
麻豆传播媒体免费观看
|
一级黄色免费大片
|
国产三级漂亮女教师
|
99久久国产综合精品女同图片
|
亚洲天堂8
|
无码人妻aⅴ一区二区三区玉蒲团
|
国产l精品国产亚洲区久久
人妻加勒比系列无码专区
亚洲老熟女与小伙bbwtv
|
www.久草
|
五月久久综合蜜桃一区
|
亚洲女人体内精汇编
|
国产性一乱一性一伧一色
|
亚洲图片视频一区
|
人人舔人人爱
|
国产欧美一区二区久久性色99
|
а天堂中文在线官网在线
|
天天玩天天操
|
一区二区三区精品在线
|
侵犯强奷高清无码
|
亚欧乱色熟女一区二区三区
|
国产精品毛片一区二区在线看舒淇
|
亚洲色精品vr一区二区
|
黑人巨茎大战白人美女
|
欧美一级淫片bbb一84
|
青青久在线
|
巴西极品性猛交
|
亚洲а∨无码2019在线观看
|
亚洲成a×人片在线观看
|
伊人色综合久久天天人守人婷
|
波多野结衣第一页
|
日本a√在线观看
|
2021最新国产在线人成
|
97无码免费人妻超级碰碰碰碰
|
欧美精品黄|
国产 校园 另类 小说区
|
99久久国产综合精麻豆
|
亚洲一区爱区精品无码
|
丰满少妇叫我吸她大乳
|
五码亚洲|
一二三区无线乱码2021香
|
亚洲国产成人爱av网站
|
天天摸夜夜添狠狠添婷婷
|
www,久久久|
欧美人与动牲交zooz乌克兰
|
黄网站色成年片在线观看
|
宅男噜噜噜66
|
久久久人成影片一区二区三区
|
97在线精品视频免费
|
中文国产在线观看
|
青青青草视频在线观看
|
77777熟女视频在线观看
|
国产乱xxxxx79国语对白
|
特黄一毛二片一毛片
|
欧美日韩亚洲一区二区三区
|
韩国乱码伦视频免费
|
99精品欧美一区二区蜜桃免费
|
国产在线精品国偷产拍
|
亚洲 欧美 日韩 精品
|
青青草原综合久久大伊人
|
色综合视频一区二区三区
|
伊人加勒比
|
亚洲天堂2013
|
午夜操一操
|
91麻豆精品国产91久久久点播时间
|
国产色欲色欱www在线
|
久久国产精品2020免费
|
无码成人网站视频免费看
|
五月香婷婷
|
无码丰满熟妇bbbbxxx
|
国产一级做a
|
狠狠躁夜夜躁人爽
|
亚洲中文字幕日产乱码高清
|
久操精品在线
|
丝袜老师高潮呻吟高潮
|
日本一二三不卡视频
|
日本视频免费高清一本18
|
亲胸揉屁股膜下刺激视频免费网站
|
亚洲三区在线观看无套内射
|
欧美整片sss
|
成人午夜做爰视频免费看
|
国产私拍|
农村乡下女人毛片
|
亚洲一区,二区
|
欧洲色视频
|
久久婷婷色五月综合图区
|
国产白丝精品91爽爽久久
|
秋霞影院午夜丰满少妇在线视频
|
真人毛毛片|
欧美日韩人成视频在线播放
|
人人妻人人狠人人爽天天综合网
|
中国中文字幕伦av在线看片
|
欧美丰满熟妇xxxx性ppx人
|
亚洲三级黄色
|
92av视频
|
伊伊总综合网
|
日韩亚洲产在线观看
|
www.少妇|
免费一级特黄视频
|
欧美乱妇狂野欧美在线视频
|
午夜精品久久久久久99热小说
|
精品久久8x国产免费观看
|
h成人在线观看
|
天天操人人
|
精品国产性色无码av网站
|
久久精品黄色
|
午夜在线国语中文字幕视频
|
欧美 日韩 亚洲 在线
|
岛国av免费看|
91在线网站|
精品国产亚洲一区二区三区
|
国产爱豆剧传媒在线观看
|
日产中文字幕在线观看
|
50路60路老熟妇啪啪
|
爽妇网av|
日韩中文字幕影院
|
男人的天堂在线观看av
|
日本三级不卡视频
|
交换交换乱杂烩系列yy
|
成人在线视频一区二区
|
亚洲无av码一区二区三区
|
毛片女人18片毛片点击进入
|
欧美牲交a欧美牲交aⅴ图片
|
精品无人码麻豆乱码1区2区
|
成人亚洲欧美
|
高清偷自拍第1页
|
无码人妻久久一区二区三区免费
|
精品人妻系列无码一区二区三区
|
日韩欧美精品有码在线
|
男人的天堂视频在线观看
|
色图插插
|
国产精品18久久久久白浆软件
|
成人啪啪
|
巨爆乳无码视频在线观看
|
性感少妇av
|
亚洲激情国产
|
国产玖玖玖玖精品电影
|
久久久久国产免费
|
四虎影院网
|
香蕉久久国产av一区二区
|
精品国产成人
|
国产精品久久久久久久免费观看
|
国产亚洲福利
|
久久综合给合久久国产免费
|
欧美一区二区视频在线播放
|
国产亚洲精品久久久久久男优
|
高中国产开嫩苞实拍视频在线观看
|
影音先锋熟女少妇av资源
|
欧美成人天天综合在线
|
免费看无码自慰一区二区
|
漂亮人妻洗澡被公强 日日躁
|
插我舔内射18免费视频
|
中文字幕永久免费视频
|
午夜亚洲理论片在线观看
|
国产精品拍国产拍拍偷
|
亚洲国产桃花岛一区二区
|
91精品大片
|
www.日本黄色片|
美日韩三级
|
99精品一级欧美片免费播放
|
色视频一区二区
|
欧美日韩中文字幕在线播放
|
国产视频欧美
|
免费特级黄毛片在线成人观看
|
国产夫妻在线观看
|
91鲁|
亚洲精品九九
|
亚洲男人天堂影院
|
国产av午夜精品一区二区入口
|
直接在线观看的三级网址
|
无码精品国产va在线观看dvd
|
免费在线观看不卡av
|
2019最新国产不卡a
|
久久99亚洲精品久久频
|
骚女人干起来舒服视频在线
|
午夜精品久久久内射近拍高清
|
在线一级片
|
日韩精品视频大全
|
久久精品国产欧美日韩99热
|
中文在线а√在线天堂中文
|
亚洲成在人
|
www.蜜桃av.com
|
国产乱人伦偷精品视频免
|
国产在线拍揄自揄视频网试看
|
在线亚洲高清揄拍自拍一品区
|
一本色道久久综合狠狠躁
|
人妻熟女一区二区aⅴ水野朝阳
|
国产在线第一区二区三区
|
色悠久久久久综合欧美99
|
日批短视频
|
欧美久久久
|
亚洲色p|
亚洲最大成人av
|
国内精品人妻久久毛片app
|
国产又粗又爽又黄的视频
|
日本网站一区
|
亚洲国产综合精品中久
|
免费观看又色又爽又黄6699
|
国产精品av久久久久久久久久
|
男人添女人囗交做爰的技巧
|
国产精品91在线
|
一个色综合国产色综合
|
国产精品一区二区av片
|
男女猛烈xx00免费视频试看
|
在线观看视频www
|
xxx综合网|
99日本精品永久免费久久
|
jizz一区二区三区
|
国产成人精品亚洲线观看
|
日韩精品在线免费观看视频
|
999精欧美一区二区三区黑人
|
日韩精品久久久久久久九岛
|
亚洲欧洲天堂
|
一区不卡在线观看
|
无码av天堂一区二区三区
|
国产草草影院ccyycom
|
国产视频欧美视频
|
欧美黑人性猛交xxx
爱情岛aqdlt国产论坛
|
国内精品久久久久久无码不卡
|
国产av巨作丝袜秘书
|
免费毛片全部不收费的
|
成人a级大片
|
国产真实伦在线观看视频
|
av鲁丝一区鲁丝二区鲁丝三区
|
成人欧美一区二区三区黑人孕妇
|
国产在线观看一区二区
|
国模小黎自慰337p人体
|
国产黄毛片
|
99精品视频在线导航
|
午夜福利电影
|
久久婷婷一级淫片aaa谢语彤
|
久久av无码精品人妻系列试探
|
午夜av亚洲一码二中文字幕青青
|
欧妇女乱妇女乱视频
|
久草在线免费资源
|
伊人网在线观看
|
精品人妻伦一二三区久久aaa片
|
国产精成人品一区
|
国产成人综合怡春院精品
|
精品日产1区2卡三卡麻豆
|
国产鲁鲁
|
www.69视频|
美女爽到呻吟久久久久
|
77777亚洲午夜久久多喷
|
久久婷婷激情
|
日日干日日干
|
欧美日韩第一区
|
国产成人8x人网站视频在线观看
|
色婷婷啪啪|
欧美牲交a欧美牲交aⅴ久久
|
香蕉精品亚洲二区在线观看
|
国产私拍福利精品视频
|
久久精品18
|
在线日韩视频
|
女人18毛片水真多免费看
|
一本一道波多野结衣av黑人
|
日本另类xxxx
|
亚洲h在线观看
|
久久精品.com|
99视频在线看
|
成 人色 网 站 欧美大片在线观看
|
天天射天天干天天色
|
手机在线日韩av
|
国产精品蜜臀av免费观看四虎
|
欧美日韩123区
|
婷婷777|
人妻无码熟妇乱又伦精品视频
|
久草在线最新视频
|
久久精品国产亚洲a∨麻豆
国内外精品激情刺激在线
成人国产亚洲
|
欧美不卡视频一区发布
|
99re久久精品国产
|
亚洲草逼视频
|
麻豆国产av丝袜白领传媒
|
99免费在线
|
伊人久久成人网
|
韩国三级丰满少妇高潮
|
久草免费在线视频
|
在线高清理伦片a
|
国产精品自在拍首页视频
|
99精品国产久热在线观看
|
少妇9999九九九九在线观看
|
亚洲色帝国综合婷婷久久
|
国产精品无码制服丝袜
|
精品乱人伦
|
日出水了特别黄的视频
|
亚洲国产欧美国产第一区
|
五十路丰满中年熟女中出
|
久久久精品免费看
|
久久天天躁狠狠躁夜夜网站
|
五月综合激情日本mⅴ
|
97色伦网
|
2019精品手机国产品在线
|
国产免费av片在线
|
狠狠色婷婷丁香综合久久韩国电影
|
免费全部高h视频无码软件
亚洲成人另类
|
亚洲中文字幕日产乱码小说
|
手机成人av在线
|
东北少妇下蹲露大唇
|
纯肉无遮挡h肉动漫在线观看国产
|
国产小视频免费
|
久久99精品久久久久久久清纯
|
成人精品视频一区二区三区
|
日本乱码伦视频免费播放
|
www成人啪啪感受
|
欧亚乱熟女一区二区三区在线
|
亚洲在线第一页
|
国产成人精品免高潮在线观看
|
国产入口
|
最近中文字幕免费mv在线视频
|
国产成人精品午夜福利在线播放
|
污污污污污污污网站污
|
亚洲色成人www永久网站
|
亚洲福利二区
|
色999韩
|
日韩久久一区二区
|
天天干天天狠
|
亚洲欧美另类中文字幕
|
看全色黄大色黄女片爽名优
|
av成人天堂|
动漫美女羞羞视频网站中文
|
国产suv精品一区二区四区三区
|
国产亚洲曝欧美曝妖精品
|
激情伊人网
|
亚洲国产精品无码专区在线观看
|
免费女人18毛片a毛片视频
|
男女无套免费视频网站动漫
|
日产精品高潮呻吟av久久
|
国产免费一区二区视频
|
欧美精品 日韩
|
国内免费毛片
|
巨人精品福利官方导航
|
衣服被扒开强摸双乳18禁网站
|
国产欧美一区二区精品秋霞影院
|
xxxxxxx国产
|
久色影视|
国产精品另类
|
日本在线视频不卡
|
午夜免费av啪啪噜噜
|
免费av影片
|
少妇扒开双腿让我看个够
|
一级男女裸片
|
女同志亚洲人在狂欢
|
日韩av中文字幕在线
|
三级国产在线
|
日日摸夜夜添夜夜添无码免费视频
|
免费裸体无遮挡黄网站免费看
|
激情六月天
|
色狠狠成人综合网
|
www.毛片|
五月婷婷综合激情网
|
欧美成年人视频在线观看
|
你懂的视频在线看
|
免费观看的无遮挡av
|
一级黄色大片网站
|
人妻熟女少妇一区二区三区
|
免费黄色美女网站
|
国产剧情一区二区
|
av在线网址观看
|
亚洲精品少妇
|
日韩成人av无码一区二区三区
|
最新黄色毛片
|
欧美日批片
|
亚洲精品理论电影在线观看
|
欧美亚洲国产日韩一区二区
|
婷婷色爱区综合五月激情韩国
|
国产69精品久久久久乱码免费
|
欧美国产一区二区三区激情
|
亚洲男人的天堂成人www
|
亚洲人成人网站18禁
|
国产精品va在线观看丝瓜影院
|
男人用嘴添女人下身免费视频
|
www.久久综合|
一本到中文无码av在线精品
|
香蕉久久久久久av综合网成人
|
2021亚洲卡一卡二新区入口
|
久草在线观看福利视频
|
蜜臀一区二区三区
|
欧美一区二区三区四区啪啪
|
久久精品视频亚洲
|
婷婷久久一区二区三区
|
精品淑女少妇av久久免费
|
国产在线欧美日韩精品一区
|
波多野结衣在线视频网站
|
69亚洲乱人伦
|
男人天堂免费视频
|
好男人好资源在线观看免费视频
|
亚洲高清在线免费
|
日韩精品久久久久久久
|
人妻精油按摩bd高清中文字幕
|
国产一区二区三区久久久久久久久
|
国内少妇自拍
|
天堂狼人mv
|
日韩一区二区三区福利视频
|
日本不卡网站
|
性一交一乱一伦一色一情孩交
|
国产精品av久久久久久网址
|
一中文字幕日产乱码va
|
国产精品国产三级国产aⅴ
天天摸夜夜添狠狠添高潮出水
|
超级碰碰色偷偷免费视频
|
羞羞国产一区二区三区四区
|
欧美一级影院
|
日韩欧美一区二区三区永久免费
|
免费无码黄动漫在线观看
|
丝袜天堂网
|
日韩城人网站
|
日产区一线二线三av
|
亚洲国产精品视频在线
|
国产色系视频在线观看
|
国产高潮久久
|
亚洲在线观看免费
|
女女女女bbbb日韩毛片
|
欧美日韩一区二区三区在线观看免费
|
高潮潮喷奶水飞溅视频无码
|
99久久精品日本一区二区免费
|
亚洲精品偷拍影视在线观看
|
小13箩利洗澡无码视频免费网站
|
欧美蜜桃视频
|
视频一区视频二区制服丝袜
|
久久永久免费人妻精品下载
|
中文乱码免费一区二区
|
日韩亚洲第一页
|
亚洲日韩性欧美中文字幕
|
亚洲gv白嫩小受在线观看
|
亚洲视频欧洲视频
|
国产欧美亚洲精品第1页青草
|
狠狠色伊人亚洲综合成人
|
国产毛片一区二区三区软件
|
手机看片午夜
|
jizzjizz少妇亚洲水多
|
天天干天天爽天天操
|
乱人伦视频中文字幕
|
无码精品国产一区二区三区免费
|
欧洲卡一卡二卡三爱区
|
无码男男作爱g片在线观看
我把护士日出水了视频90分钟
|
av中文字幕在线免费观看
|
日韩国产欧美一区二区三区
|
九色91丨porny丨丝袜
|
毛片网站在线观看视频
|
亚洲精品久久久久久一区
|
欧美精品一区免费
|
欧美中日韩免费观看网站
|
精品国偷自产在线
|
亚色中文|
色视频www在线播放国产人成
|
亚洲国产精品成人影片久久
|
成年人视频在线免费看
|
国产 日韩 欧美 精品
|
精品视频一区二区
|
大岛优香中文av在线字幕
|
成年人的天堂
|
国产成人在线观看免费
|
亚洲丝袜一区
|
国产成人麻豆亚洲综合精品
|
国产精品久久久久久久毛片动漫
|
亚洲欧洲日产国无高清码图片
|
亚洲爆乳无码一区二区三区
|
中文字幕人成人乱码亚洲影视的特点
|
国产亚洲日韩av在线播放不卡
|
色综合亚洲一区二区小说性色aⅴ
|
精品国产综合区久久久久久
|
日日碰日日摸夜夜爽无码
|
真实国产老熟女粗口对白
|
久久七|
国产精选污视频在线观看
|
亚洲成品网站源码中国有限公司
|
日本无遮真人祼交视频
|
国产福利免费视频不卡
|
欧美亅性猛交内射
|
亚洲 欧美 清纯 在线 制服
|
国产亚洲美女精品久久久2020
|
人妻无码不卡中文字幕系列
|
欧美猛少妇色xxxxx
|
青青青爽在线视频免费观看
|
精品蜜臀av在线天堂
|
综合久久久久久久
|
久久精品国产久精国产爱
|
国产极品视觉盛宴
|
亚洲99影视一区二区三区
|
日韩免费福利视频
|
国产精品美女久久久久久
|
久久只有这里有精品4
|
中文字幕123|
亚洲女同性同志熟女
|
国产女爽爽精品视频天美传媒
|
a黄色一级片
|
国产精品对白久久久久粗
|
久久精品亚洲中文字幕无码网站
|
亚洲人成线无码7777
|
色欲色香天天天综合无码www
|
成本人无码h无码动漫在线网站
|
国产成人免费9x9x人网站视频
|
伊人色视频
|
免费一级淫片a人观看69
|
亚洲激情一区二区
|
日本乱码一区二区三区不卡
|
多毛小伙内射老太婆
|
少妇下蹲露大唇无遮挡
|
欧美午夜一区二区三区精美视频
|
777米奇影视第四色
欧美日韩国产精品
|
极品主播的慰在线播放
|
亚洲人体一区二区
|
久久99精品久久久久
|
久久久久久国产精品免费无码
|
性无码免费一区二区三区在线网站
|
欧美一区二区最爽乱淫视频免费看
|
亚洲 都市 无码 校园 激情
|
国产精品xxx在线观看www
|
国产亚洲精品线视频在线
|
国产激情久久久久影院小草
|
日本亚洲欧洲另类图片
|
99热免费看
|
国产毛片毛片毛片毛片
|
美女高清视频免费视频
|
中文字幕国产在线观看
|
又粗又硬又大又爽免费视频播放
|
久久福利影院
|
色婷婷六月亚洲综合香蕉
|
无码亲近乱子伦免费视频在线观看
|
一个人免费观看视频www中文
|
又爽又黄又无遮挡网站动态图
|
亚洲人成人一区二区三区
|
成人麻豆精品激情视频在线观看
|
插入综合网
|
日本三级带日本三级带66
|
老熟女重囗味hdxx70星空
|
色婷婷五月综合欧美图片
|
日本二区在线观看
|
少妇av导航|
99国内精品久久久久久久软件
|
国产免费的又黄又爽又色
|
老熟女多次高潮露脸视频
|
国产成年女人特黄特色毛片免
|
黄色免费入口
|
中国一级黄色毛片
|
337p人体粉嫩久久久红粉影视
|
国产免费久久精品99re丫丫
|
91网视频
|
亚洲五月综合缴情在线
|
午夜成年奭片免费观看
|
日韩在线色
|
国语自产偷拍在线观看
|
中文字幕第十二页
|
久久精品a一国产成人免费网站
|
亚洲人成毛片在线播放
|
亚洲色成人网站www永久
|
天天看夜夜操
|
怡春院久久国语视频免费
|
色悠久久久久久久综合
|
高清偷自拍第1页
|
人妻丝袜无码国产一区
|
少女韩国电视剧在线观看完整
|
98国产精品视频
|
91网站在线免费看
|
色婷婷一区二区三区
|
日本无遮羞打屁股网站视频
|
北条麻妃一区二区三区av高清
|
福利姬液液酱喷水
|
深夜福利亚洲
|
日本阿v片在线播放免费
|
日本欧美一区二区三区不卡视频
|
青青热久|
亚洲视频在线一区
|
色视频综合
|
久久精品女人毛片国产
|
好男人社区资源
|
日日麻批免费视频播放
|
噼里啪啦在线看免费观看视频
|
国产夫妻自拍一区
|
久久精品人人做人人爽电影
|
女人被狂躁高潮啊的视频在线看
|
99久久精品久久久久久ai换脸
|
麻豆精品一区二区综合av
|
无码帝国www无码专区色综合
|
尤物tv国产精品看片在线
|
精品国产这么小也不放过
|
欧美亚洲国产成人一区二区三区
|
国产成人综合久久免费导航
|
日韩特黄一级欧美毛片特黄
|
视频在线a
|
日韩成人三级
|
男人免费网站
|
狠狠插日日干
|
日本黄色一级片免费看
|
日韩欧美国产免费
|
日韩欧美视频二区
|
wwwxx日本|
亚洲欧洲日产国码无码久久99
|
国产性xxxx18免费观看视频
|
欧美黄色a级
|
男生白内裤自慰gv白袜男同
|
青乐娱精品视频一国产分类
|
波霸ol色综合久久
|
亚洲国产一区二区在线观看
|
久久99精品久久久久久久久久久久
|
亚洲日韩精品射精日
|
中日韩精品视频在线观看
|
天天看天天做
|
国产一级精品片
|
国产20页
|
五月天婷婷爱
|
国产精品日韩欧美一区二区三区
|
亚洲精品乱码久久久久久麻豆不卡
|
国产无套粉嫩白浆内谢网站
|
亚洲一区黄色
|
av网站在线免费观看
|
蜜臀av午夜一区二区三区
|
日韩欧美大片免费观看
|
三级黄色毛片视频
|
大陆三级午夜理伦三级三
|
男人进女人下部全黄大色视频
|
青青青国产在线观看资源
|
亚洲激情欧美激情
|
亚洲欧美综合国产精品二区
|
午夜精品福利影院
|
久久久96|
免费的黄网站在线观看
|
97超级碰碰碰免费公开在线观看
|
国产熟睡乱子伦视频在线观看
|
丰满少妇偷人51视频在线观看
|
女人扒开屁股桶爽30分钟
|
黄色一级片欧美
|
久草在线手机
|
伊人热热久久原色播放www
|
国产精品成人无码a片在线看
|
护士的奶头又大又白又好摸
|
麻豆精品乱码一二三区别蜜臀在线
|
人人爽人人爽人人片av
|
国产精品嫩草影院精东
|
国产午夜精品无码
|
国产理论剧情大片在线播放
|
插菊花综合
|
亚洲精品一区二区丝袜图片
|
噜噜久久噜噜久久鬼88
|
粉嫩极品美女国产在线观看
|
毛茸茸熟妇张开腿呻吟
|
成人片黄网站色大片免费观看
|
久久福利网站
|
又色又爽又黄无遮挡的免费视频
|
91免费看nba国产91免费看nba国产
|
国产后入又长又硬
|
亚洲午夜精品久久久久久app
|
成人av网站免费
|
国产最爽乱淫视频免费
|
色先锋影音岛国av资源
|
香蕉视频一直看一直爽
|
精品国产av色一区二区深夜久久
|
91久久国产综合精品女同国语
|
国产在线超清日本一本
|
青草伊人久久综在合线亚洲
|
欧美日韩精品在线观看视频
|
嫩草av91|
国变精品美女久久久久av爽
|
久久se精品一区精品二区
|
精品久久久久久成人av
|
国产精品自拍一区
|
视频一区在线免费观看
|
4455成人免费观看
|
亚洲爆爽
|
天天舔天天干天天操
|
午夜嘿嘿嘿在线观看
|
日本三级短视频
|
国产三级全黄裸体
|
69国产成人精品二区
|
国产精品国产三级国产aⅴ下载
|
三级毛片在线看
|
中文字幕av网站
|
久久r|
国产精品入口福利
|
日日操夜夜
|
国产精品二区一区
|
天天躁夜夜躁狠狠躁2021
|
国产韩国精品一区二区三区久久
|
久久中文字幕人妻熟女
|
亚洲狼人天堂
|
国产日产亚洲系列最新美使用方法
|
麻豆画精品传媒2021一二三区
|
日本亚洲国产一区二区三区
|
国产高清在线精品一区小说
|
欧美韩日
|
一本久道高清无码视频
|
在线看片免费人成视频福利
|
国产麻豆一精品一av一免费软件
|
狂野欧美性猛交xxxxx视频
|
另类激情综合网
|
99久久夜色精品国产亚洲
|
人妻中出无码中字在线
|
蜜桃av鲁一鲁一鲁一鲁俄罗斯的
|
国产黄a三级三级三级
|
亚洲a片v一区二区三区有声
|
亚洲精品国产福利一区二区
|
性生交大片免费看
|
在线97|
亚洲精品男女
|
亚洲精品一区二区三区不卡
|
永久不封国产毛片av网煮站
|
人妻美妇疯狂迎合系列视频
|
亚洲人av在线无码影院观看
|
日韩无套无码精品
|
国产免费观看久久黄av片
|
欧美jizz18性欧美视频
|
免费观看的av
|
国产欧美精品区一区二区三区
|
超碰在线人人干
|
久久www成人免费网站
|
影音先锋中文字幕资源
|
一边摸一边做爽的免费视频日本
|
久久午夜无码鲁丝片午夜精品
|
91av久久
|
国产精品网站在线观看免费传媒
|
国产精品99久久久久人中文网介绍
|
毛片在线免费
|
欧美少妇bbb
|
一区二区三区四区在线 | 网站
|
成人污污www网站免费丝瓜
|
亚洲乱码一区二区三区在线观看
|
邪恶肉肉全彩色无遮盖
|
一本综合丁香日日狠狠色
|
欧美亚洲福利
|
欧美猛交免费
|
青草精品国产福利在线视频
|
精品国产乱子伦
|
日韩影库
|
日本免费不卡一区在线电影
|
狠狠操天天操
|
国产又粗又硬的视频
|
www.xxx日本com|
亚洲精品亚洲人成在线观看麻豆
|
91九色国产ts另类人妖
|
麻豆产精品一二三产区区
|
中文字幕欧美久久日高清
|
天堂在线.www天堂在线资源
|
韩国一级一片高清免费观看
|
性欧美13处14破xxx极品
|
福利社午夜影院
|
亚洲九一
|
综合网国产
|
狠狠色综合色综合网站久久
|
国内丰满少妇猛烈精品播
|
在线中文字幕一区二区
|
日本按摩高潮
|
亚洲五月婷
|
成年无码动漫av片在线尤物
|
绯色av蜜臀一区二区中文字幕
|
亚洲精品国产欧美一二区
|
成人免费黄色网址
|
日本久久综合久久综合
|
91久久嫩草影院一区二区
|
中文无码一区二区视频在线播放量
|
日日躁夜夜躁狠狠躁夜夜躁
|
亚洲人成网站在线播放2019
|
最新的国产成人精品2022
|
成人在线视频你懂的
|
四虎永久在线高清国产精品
|
香蕉av在线播放
|
午夜精品久久久久久久99热浪潮
|
羞羞国产一区二区三区四区
|
影音先锋在线中文字幕
|
久青草影院在线观看国产
|
亚洲国产精品99久久久久久久久
|
大又大粗又爽又黄少妇毛片
|
欧美大码bbw搡bbbb搡小说
|
香蕉手机网
|
成年美女黄网站色大免费全看
|
天天操夜夜爱
|
欧美黄视频在线观看
|
欧美成人久久
|
大j8福利视频导航
|
国产丝袜美女一区二区三区
|
久久国产福利
|
中文字幕卡二和卡三的视频
|
好爽插到我子宫了高清在线
|
在线免费看黄
|
国产精品久久自在自线青柠
|
国产精品高潮呻吟av久久4虎
|
又深又粗又爽又猛的视频
|
在线播放侵犯新任女学生
|
少妇高潮a视频
|
色狠狠av老熟女
|
亚洲国产一区二区三区四区电影网
|
a级毛片蜜桃成熟时2在线播放
|
女人被狂躁高潮啊的视频在线看
|
亚洲免费看av
|
97精品久久
|
伊人久久大香线蕉无码
|
日本高清一区免费中文视频
|
欧美猛交免费看
|
亚洲成 人 综合 亚洲欧洲
|
欧美啊v
|
好吊色欧美一区二区三区四区
|
2021天天躁夜夜看
|
国产亚洲精品久久情网
|
www..com黄色
|
欧美精品videos另类
|
精品无码国产不卡在线观看
|
日本高清不卡中文字幕视频
|
国产成人精品一区二区三区免费
|
伊人精品久久久久中文字幕
|
www成人网
|
久久精品aⅴ无码中文字字幕不卡
|
国产手机在线无码播放视频
|
成人一区二区免费中文字幕视频
|
亚洲狠狠丁香综合一区
|
av大全免费|
少妇的丰满人妻hd高清
|
亚洲天堂免费在线观看视频
|
熟妇人妻av中文字幕老熟妇
|
亚洲尤物在线
|
91成人精品一区在线播放
|
久久精品农村毛片
|
欧美理伦黑寡妇艳妇
|
欧美精品一区二区三区蜜桃视频
|
亚洲美女在线视频
|
91播放在线
|
婷婷精品视频
|
色约约网站|
欧美日本在线
|
在线日本国产成人免费不卡
|
中国少妇初尝黑人巨大
|
女人与拘做受全过程免费视频
|
日本韩国三级在线观看
|
午夜理伦三级理论三级
|
国产成人av大片大片在线播放
|
久久青青视频
|
www男人的天堂
|
国产一区二区三区四区成男人
|
色眯眯影院
|
性开放天体www偷拍
少妇a级
|
一插综合网
|
国产另类xxxx
|
国产又粗又硬又爽又黄的视频
|
国产在线视精品在一区二区
|
中文字幕日本精品一区二区三区
|
天堂av播放
|
久久久久久臀欲欧美日韩
|
男人扒开女人内裤强吻桶进去
|
日韩欧美群交p片內射中文
国产精品亚洲片夜色在线
毛片无码国产
|
青娱乐免费在线视频
|
91色网址
|
欧美精品一区免费
|
欧美精品乱人伦久久久久久
|
久久亚洲精品国产精品婷婷
|
日韩欧美视频一区
|
调教+趴+乳夹+国产+精品
|
在线免费观看欧美大片
|
风韵少妇性饥渴推油按摩视频
|
精品久久久久久久久午夜福利
|
免费大香伊蕉在人线国产卡
|
97人人爱
|
成人18aa黄漫免费观看
|
天美传媒精品
|
色狗网站
|
小说区图片区视频区
|
久久99亚洲网美利坚合众国
|
婷婷综合激情
|
国产精品suv一区二区88
|
欧美丰满熟妇xxxx性
|
色婷婷久久久swag精品
|
韩国三级无码hd中文字幕
|
毛片无码国产
|
亚洲人成网站在线播放大全
|
精品视频无码一区二区三区
|
69做爰视频在线观看
|
亚洲丝袜一区二区
|
久久影院一区二区
|
日韩成人小视频
|
少妇翘臀亚洲精品av图片
|
久久亚洲精品中文字幕无码
|
男人吃奶摸下挵进去好爽
|
永久免费黄色大片
|
日韩欧美日本
|
国产亚洲日韩在线一区二区三区
|
亚洲国产精品热久久
|
国内精品伊人久久久久网站
|
日日摸日日碰夜夜爽亚洲综合
|
日韩精品中文字幕在线
|
精品国产毛片
|
久久久久久夜
|
又粗又长av|
成人免费视频大全
|
亚洲成a∨人在线播放欧美
天天cao
|
1000部拍拍拍18勿入免费视频下载
|
少妇真实自偷自拍视频6
|
一区二区三区在线 | 欧洲
|
亚洲图片偷拍区
|
中文字幕人妻偷伦在线视频
|
色综合中文综合网
|
四虎国产精品永久在线无码
|
国产男女猛烈无遮挡a片漫画
|
伊人久久精品久久亚洲一区
|
国产目拍亚洲精品99久久精品
|
91久久精品一区二区
|
天堂视频免费
|
国产成人无码一区二区在线播放
|
国产无遮挡18禁无码网站免费
|
2021国产精品成人免费视频
|
夜夜揉揉日日人人青青
|
av黄色在线
|
成人午夜在线观看
|
岛国伊人
|
色婷婷综合久久中文字幕雪峰
|
热热色原网址
|
中文字幕av一区乱码
|
久草在线看片
|
草草影院精品一区二区三区
|
久久精品人人槡人妻人
|
9l视频自拍九色9l视频最新
|
成人99
|
久久综合给合久久国产免费
|
人人网碰人人网超
|
色多多av|
欧美日韩人成综合在线播放
|
天天夜夜爽
|
久久久久99精品成人片
|
国产女人伦码一区二区三区不卡
|
少妇被躁爽到高潮无码文
|
韩国三级大全久久网站
|
五月天婷婷网站
|
日本久久久www成人免费毛片丨
|
国产精品www
|
日本猛少妇色xxxxx猛叫
|
国产精品久久久久久久妇
|
久久国产精品无码一区二区三区
|
中国a毛片|
少妇一区二区三区
|
久久久久爱
|
另类中文字幕
|
大胸喷奶水的www的视频网站
|
中文字幕av久久激情亚洲精品
|
国产人成高清在线视频99
|
天天干天天做
|
中国杭州少妇xxxx做受
|
天天视频国产
|
一个人看的免费视频www中文字幕
|
人妻无码一区二区三区tv
|
日本免费视频在线观看
|
国产亚洲日韩在线一区二区三区
|
中文字幕精品视频
|
久插视频
|
国产又粗又猛又爽又黄的视频先
|
亚洲不卡在线观看
|
福利视频精品
|
波多老师无码av中字专区
|
强制高潮xxxxhd日本
|
亚洲日韩欧美在线无卡
|
性猛交富婆xxxⅹ乱大交
|
人妻aⅴ中文字幕无码
|
久久咪咪
|
亚洲福利一区二区
|
日本一区二区在线免费观看
|
成人免费ā片在线观看
|
亚洲一区欧美在线
|
a级片一区二区
|
91一起草|
91自产|
亚洲欧美日韩国产成人精品影院
|
99成人免费视频
|
国产免费丝袜调教视频免费的
|
国产成人av在线免播放app
|
中文字幕视频在线播放
|
综合三区后入内射国产馆
|
亚洲欧美日韩第一页
|
99国产在线观看
|
曰本女人牲交高潮视频
|
日本老熟妇毛茸茸
|
亚洲另类成人小说综合网
|
97视频在线精品国自产拍
|
国产精品18久久久久久久网站
|
冲田杏梨aaa久久av
|
亚洲区免费中文字幕影片|高清在线观看
|
狠狠色狠狠色综合网
|
强制中出しバス痴汉在线观看
|
亚洲综合视频在线
|
欧美xxxx做受性欧美88
|
亚洲欧美综合区自拍另类
|
蜜臀av无码国产精品色午夜麻豆
|
av免费大全|
av色综合久久天堂av色综合在
|
亚洲精品色情aⅴ色戒
|
一夲道无码人妻精品一区二区
|
国产 日韩 欧美 在线
|
国产20页|
偷偷操99
|
丁香花在线免费观看高清视频
|
色香阁综合无码国产在线
|
四虎成人精品无码
|
国产精品无码综合区
|
宅男午夜成年影视在线观看
|
不卡中文|
国产精品久久久久久2021
|
久久久久久久爱
|
狠狠色狠狠色综合日日五
|
18禁黄久久久aaa片
|
欧美日韩亚洲国产综合乱
|
双腿张开被9个黑人调教影片
|
中产乱码中文在线观看免费软件
|
亚洲中文字幕无码天然素人
|
亚洲一级色片
|
日本午夜无人区毛片私人影院
|
欧洲妇女成人淫片aaa视频
|
zzjj国产精品一区二区
|
糖心vlog精品一区二区
|
亚洲a爱|
国产农村妇女毛片精品久久
|
强h辣文肉各种姿势h在线视频
|
成人免费毛片视频
|
欧美亚洲高清
|
av区无码字幕中文色
|
999热在线
|
亚洲а∨天堂2019无码
|
欧洲熟妇色xxxx欧美老妇软件
|
久久精品一区二区三区av
|
欧美成人看片黄a免费看
|
熟睡人妻被讨厌的公侵犯
|
午夜美女久久久久爽久久
|
欧美日韩1
|
无码h黄动漫在线播放网站
青青青国产在线视频
|
二区在线视频
|
久久久99精品免费观看
|